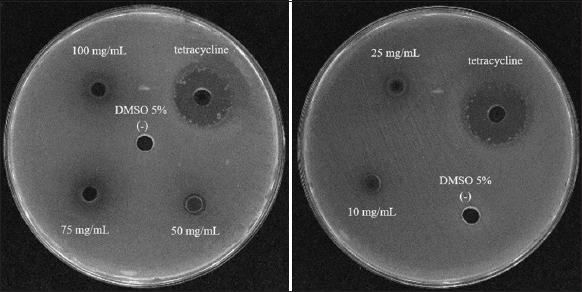

1. INTRODUCTION
Shrimp is one of the most exported products in Vietnam. In the first quarter of 2025, shrimp exports to the European Union (EU) exceeded 107 million USD. Of these, whiteleg shrimp (Litopenaeus vannamei) remains the key commodity, accounting for about 87 million USD, accounting for about 81% of the total shrimp export value to the EU, up 31% over the same period last year [1].
Despite advances in aquaculture development and the increasing adoption of modern shrimp farming systems, the industry continues to face serious challenges, especially in disease management. Among them, white feces disease (WFD) is one of the most common and persistent problems in shrimp farming. WFD affected approximately 719 ha of shrimp ponds in the main farming provinces, including Soc Trang, Bac Lieu, Tra Vinh, and Ca Mau in 2022 [2].
WFD is still a significant problem for white-leg shrimp farming. Although it does not cause mass mortality like acute hepatopancreatic necrosis disease, early mortality syndrome, or white spot syndrome virus, WFD spreads rapidly in an epidemic pattern, slows shrimp growth, and negatively impacts overall productivity and economic returns. The disease is mainly associated with an imbalance in the intestinal microbiota of shrimp, in which a high abundance of curved rod-shaped bacterial cells is found in the white midgut. In the digestive tract and pond water of WFD-affected shrimp, some Vibrio species have been identified, including Vibrio harveyi, Vibrio alginolyticus, Vibrio mimicus, Vibrio parahaemolyticus, Vibrio anguillarum, Vibrio fluvialis, Vibrio vulnificus, Vibrio damselae, and Vibrio cholerae [3-5].
Traditional medicine emphasizes the potential of bioactive compounds from plants in combating pathogenic bacteria. Melaleuca (Myrtle family) is a tree species widely distributed in Vietnam, especially in mangrove forests in Kien Giang, Ca Mau, and Dong Thap provinces.
This tree grows vigorously on alluvial and acidic soils and contributes significantly to coastal protection (seawalls and wave barriers). In addition, Melaleuca leaves have significant analgesic, antibacterial, and anti-allergic properties.
The medicinal potential of Melaleuca extract to inhibit bacteria, fungi, and viruses has been demonstrated in several recent studies. The stem inhibits Propionibacterium acnes ATCC 6919, the leaves inhibit coronavirus, and the flowers and fruits inhibit Escherichia coli ATCC 25922 and Candida albicans ATCC 10231 [6-8]. More than 30 bioactive compounds have been identified in the methanol extract of Melaleuca leaves. The main ingredients include cyclopropa[c,d]pentalene-1,3-dione, hexahydro-4-(2-methyl-2-propenyl)-2,2,4-trimethyl, docosane, 1H-Indene, 1-ethylideneoctahydro-7a-methyl, epiglobulol, (−)-oxidoselina-1,3,7(11)-trien-8-one, globulol, (+)-spathulenol, 2-Heptanone, 6-(3-acetyl-2-methyl-1-cyclopropen-1-yl)-6-methyl, veridiflorol [9].
In some previous studies showing the antibacterial potential of Melaleuca extract, and considering the current prevalence of WFD in shrimp, which is mainly caused by an imbalanced intestinal microbiota. This study aimed to evaluate and expected to clarify the antibacterial activity of Melaleuca methanol leaf extract against Vibrio spp. isolated from WFD-affected shrimp. Therefore, suggest a promising biological approach for controlling Vibrio spp. as part of a feasible strategy for the prevention and treatment of WFD in shrimp farming.
2. MATERIALS AND METHODS
2.1. Sample Collection
White-leg shrimp showing signs of WFD have been observed in Cu Lao Dung district, Soc Trang province. Symptoms of shrimp affected by WFD include opaque white intestines with a thin yellow layer covering the hepatopancreas, as well as white or yellow feces floating on the water surface. Additionally, the shrimp exhibit signs of lethargy, slow growth, reduced feeding rates, and loose shells [10]. Melaleuca leaves were collected in Hamlet 6, Luong Nghia Commune, Long My District, Hau Giang Province, Vietnam. Melaleuca leaves were collected in the morning and transported to the laboratory.
2.2. Isolation of Vibrio spp.
The shrimp were sterilized with 70% alcohol to remove bacteria on the surface. About 1 g of intestines and hepatopancreas were dissected and homogenized in 9 mL of a 0.9% NaCl solution. The sample was diluted to a concentration of 10−3 and spread in 100 µL of the solution on the TCBS medium. The sample was incubated at room temperature (27°C ± 3) for 24 h, selecting typical colonies with blue and yellow colors [11]. The bacterial isolates were preserved by combining them with TSB medium and glycerol in a 7:3 volume ratio and then stored at −4°C.
2.3. Observe the Colony and Biochemical Character
Colonial morphology was observed under a stereomicroscope and described in terms of color, form, elevation, margin, and colony diameter after 24 h on the TCBS medium at 27°C ± 3. Cellular morphology was observed under an optical microscope with a ×100 objective. Gram stain, motility, and oxidase and catalase reactions were subsequently determined.
2.4. Identification of Vibrio spp. Bacteria and the toxR Virulence Gene
Bacterial cells were extracted using lysis buffer at a ratio of 1:1 (v/v) for 15 min and centrifuged at 12.000 rpm for 20 min. The supernatant was transferred into a new microcentrifuge tube and precipitated with 1 mL of 95o ethanol (4°C) for 30 min. Then, centrifuge again at 12.000 rpm for 20 min and retain the precipitate. DNA was washed with 500 µL of 70° ethanol and centrifuged at 12,000 rpm for 20 min (repeat this step twice). After washing, the DNA was dried in a vacuum dryer at 45–65°C for 10 min. Next, add 100 µL of 0.1X TE buffer and freeze the DNA. Vibrio spp. and the toxR virulence gene are detected by specific primer pairs [Table 1].
Table 1: Information on primer pairs used in the study.
| Primers | Sequencing | Temperature cycles | Gene | bp | References |
|---|---|---|---|---|---|
| 16S-F 16S-R | CAGGCCTAA-CACATGCAAGTC GCATCTGAGTGTCAGTATCTGTCC | 95°C–10 min, 30 cycles of the following step 95°C–1 min, 55°C–1 min, 72–1.5 min, 72°C–5 min | 16S | 700 | Montieri et al. [12] |
| toxR-F toxR-R | GTCTTCTGACGCAATCGTTG ATACGAGTGGTTGCTGTCATG | 94°C–10 min, 20 cycles of the following step 94°C–1 min, 63°C–1 min, 72–15 min, 72°C–10 min | toxR | 366 | Kim et al. [13] |
2.5. Extract Preparation
The Melaleuca leaves were transported to the laboratory, removed from the branches, washed, and dried at 40°C until a constant mass was achieved. The dried leaves were then ground into a fine powder. A total of 10 g of leaf powder was combined with 100 mL of methanol solvent and soaked repeatedly 3 times. The extract was filtered through Whatman no. 1 filter paper and evaporated in a vacuum at 50°C until a viscous extract was obtained. This extract was freeze-dried to completely remove the solvent and stored at 4°C [14]. The chemical constituents of the extract were identified by using the gas chromatography-mass spectrometry (GC-MS) method at the Can Tho Technical Center of Standards, Metrology, and Quality. The extraction efficiency (E) was determined using the following formula:
 |
2.6. The Ability to Inhibit Vibrio spp. of the Melaleuca Extract
Antibacterial activity of the extract using the disc diffusion method as described by Akshaya et al., [15]. The concentrations of the extract were investigated as 10, 25, 50, 75, and 100 mg/mL, oxytetracycline at 10 mg/mL as a positive control, and 5% dimethyl sulfoxide as a negative control. Spread 1 mL of bacteria at a density of 108 colony forming unit/mL on the TSA medium (Himedia, India), and create agar wells with a diameter of 6 mm. Add 50 µL of extract to each well and observe the zones of bacterial inhibition after 24 h.
2.7. Statistical Analysis
The experiment was repeated 3 times. Data are presented as mean ± standard deviation. The results were statistically analyzed using the analysis of variance method (Tukey’s test) with Minitab 16.0 software.
3. RESULTS AND DISCUSSION
3.1. Isolation and Identification of Vibrio spp.
Twenty-five bacterial strains were isolated from 30 shrimp samples exhibiting signs of WFD in Cu Lao Dung District, Soc Trang Province [Figure 1]. Of these, 6 strains formed yellow colonies, while 19 strains formed green colonies. Among the isolates, 6 bacterial strains had colony sizes ≥2 mm, and 19 bacterial strains had colony sizes <2 mm. All colonies floated on the medium, exhibited intact borders, and consisted of curved rod-shaped cells. All bacterial strains tested negative for Gram staining and tested positive for the presence of oxidase and catalase enzymes [Table 2].
 | Figure 1: (a) Black arrow with empty intestine, white arrow with faint liver and signs of liver atrophy; shrimp with thin body (sick, loose shell), poor pigmentation on the shell (pale color); (b and c) colony on the TCBS medium; (d) Vibrio spp.; (e) motility test. [Click here to view] |
Table 2: Characteristics of colony morphology, cells, and biochemical characteristics.
| Strains | Colony morphology | Cell morphology | Biochemical characteristics | |||||||
|---|---|---|---|---|---|---|---|---|---|---|
| Color | Form | Elevation | Margin | Diameter (mm) | Motility | Shaped | Gram | Oxidase | Catalase | |
| A1.2 | Yellow | Circular | Raised | Entire | 1.8 | + | Curved rod | - | + | + |
| A2.1 | Green | Circular | Raised | Entire | 3.0 | + | Curved rod | - | + | + |
| A3 | Green | Circular | Raised | Entire | 2.1 | + | Curved rod | - | + | + |
| A6.1 | Green | Circular | Raised | Entire | 2.1 | + | Curved rod | - | + | + |
| A6.2 | Green | Circular | Raised | Entire | 2.0 | + | Curved rod | - | + | + |
| A8.1 | Green | Circular | Raised | Entire | 2.5 | + | Curved rod | - | + | + |
| A10.1 | Green | Circular | Raised | Entire | 1.5 | + | Curved rod | - | + | + |
| B1.2 | Green | Circular | Raised | Entire | 1.2 | + | Curved rod | - | + | + |
| B5.1 | Green | Circular | Raised | Entire | 2.0 | + | Curved rod | - | + | + |
| B5.2 | Green | Circular | Raised | Entire | 2.1 | - | Curved rod | - | + | + |
| B6.1 | Green | Circular | Raised | Entire | 2.1 | + | Curved rod | - | + | + |
| B6.2 | Yellow | Circular | Raised | Entire | 1.0 | + | Curved rod | - | + | + |
| B8.1 | Yellow | Circular | Raised | Entire | 1.2 | + | Curved rod | - | + | + |
| B8.2 | Green | Circular | Raised | Entire | 2.0 | + | Curved rod | - | + | + |
| C1.1 | Yellow | Circular | Raised | Entire | 2.0 | - | Curved rod | - | + | + |
| C1.2 | Green | Circular | Raised | Entire | 0.1 | - | Curved rod | - | + | + |
| C2.1 | Yellow | Circular | Raised | Entire | 2.0 | + | Curved rod | - | + | + |
| C2.2 | Green | Circular | Raised | Entire | 1.0 | - | Curved rod | - | + | + |
| C3.2 | Green | Circular | Raised | Entire | 0.7 | - | Curved rod | - | + | + |
| C4.3 | Green | Circular | Raised | Entire | 0.1 | - | Curved rod | - | + | + |
| C6.1 | Yellow | Circular | Raised | Entire | 1.2 | + | Curved rod | - | + | + |
| C8 | Green | Circular | Raised | Entire | 1.0 | - | Curved rod | - | + | + |
| C9.1 | Green | Circular | Raised | Entire | 0.7 | + | Curved rod | - | + | + |
| C9.2 | Green | Circular | Raised | Entire | 2.0 | + | Curved rod | - | + | + |
| C10 | Green | Circular | Raised | Entire | 0.1 | - | Curved rod | - | + | + |
Observation on TCBS medium after 24 h, “−”: Negative, “+”: Positive.
On the TCBS medium, Vibrio spp. typically form green or yellow colonies. for the green colonies, V. vulnificus ATCC27562 and V. parahaemolyticus ATCC27969 do not ferment sucrose. For the other, V. alginolyticus ATCC17749 and V. harveyi ATCC14126 ferment sucrose, which reduces the pH and turns bromothymol blue in the medium to yellow [16].
3.2. Identification of Vibrio spp. with 16S rRNA Gene Primers
PCR results using 16S rRNA-specific primers identified 24 bacterial strains as Vibrio spp. [Figure 2]. However, isolates A1.2 and A10.1 weren’t Vibrio spp. despite growing on TCBS medium. Isolate A1.2 had yellow colonies with a diameter of 1.8 mm, and A10.1 had blue colonies with a diameter of 1.5 mm. Some other bacterial species can also grow on TCBS medium, including Aeromonas hydrophila (yellow) and Enterococcus spp. (yellow), Proteus mirabilis (yellow), and Staphylococcus aureus (yellow) [17].
 | Figure 2: Agarose gel electrophoresis of the 16S rRNA gene amplicons. [Click here to view] |
3.3. Identification of V. parahaemolyticus with toxR Gene Primers
Among the 24 Vibrio strains, 10 V. parahaemolyticus strains were identified as containing the toxR virulence gene [Figure 3], which is a membrane-bound regulatory protein that plays a role in virulence and fitness in Vibrio species [18].
 | Figure 3: Agarose gel electrophoresis of the toxR gene amplicons. [Click here to view] |
In the intestines of shrimp with WFD, there is a significant diversity of pathogenic bacteria. The study isolated 23 bacterial strains, including 2 strains that were not Vibrio spp., 10 strains of V. parahaemolyticus containing the toxR virulence gene, and 11 strains of Vibrio spp. Previous studies have demonstrated that the total number of Vibrio bacteria in shrimp with WFD is higher than in healthy shrimp. Additionally, there is a diversity of species, including V. vulnificus, V. fluvialis, V. parahaemolyticus, V. alginolyticus, V. damselae, V. mimicus, and V. cholerae non-O1 [3]. In a study conducted by Supono et al. [4], V. parahaemolyticus, known as the primary infected bacteria, is associated with the white-leg shrimp disease among V. vulnicus, V. parahaemolyticus, and V. alginolyticus.
Through sequence analysis of the 16S rRNA gene region, strain B5.1 was identified to exhibit a very close genetic relationship with V. parahaemolyticus, with a genetic distance of only 0.001 [Figure 4]. Although V. owensii was also identified as a closely related species in the phylogenetic tree, it did not create any amplification signal when using primers specific to the toxR gene - a widely used molecular marker for the identification of V. parahaemolyticus - as determined by Primer-basic local alignment search tool (BLAST) analysis. In this study, primer sets specific to the Vibrio genus and V. parahaemolyticus species from Montieri et al. (2010), Kim et al. (1999) [12,13], respectively, were employed. Their specificity and binding affinity were evaluated by Primer-BLAST. Subsequently, the 16S rRNA sequence (isolate B5.1) was employed to confirm its accuracy. As a consequence, this strain belongs to the V. parahaemolyticus clade based on the result of phylogenetic analysis. Therefore, the reliability of species identification based on PCR in combination with phylogenetic analysis was enhanced.
 | Figure 4: Maximum likelihood phylogenetic tree of the Vibrio spp. strain B5.1 based on 16S rRNA gene. [Click here to view] |
3.4. Melaleuca Extract
Melaleuca leaf powder is light green and fluffy. The extraction yield of Melaleuca leaf extract is 10.73%, with a moisture content of 0%. The recovery yield of Melaleuca extract by Dieu [19] is 3.37% with a moisture content of 12.21%, the difference may be due to the content and compounds inside the extract. The content of compounds inside Melaleuca leaves can vary depending on factors such as geographical location, tree age, and nutrient content in the soil.
Table 3 and Figure 5 report 13 volatile compounds and their chemical structures achieved from GC-MS analysis of the methanolic Melaleuca extract. The total peak area accounted for 100%, reflecting the high extraction efficiency and purity of the sample. The majority of the detected components were eugenol methyl ether (60.08%, retention time of 13.412 min). Additionally, the others were 1,2,6-hexanetriol (4.88%), allyl pentanoate (6.63%), and α-farnesene (11.10%). Moreover, monoterpenes and sesquiterpenes, namely β-caryophyllene, α-caryophyllene, α-cubebene, and caryophyllene oxide, were minor.
Table 3: The chemical compounds in Melaleuca extract.
| No. | Bioactive compound | Concentrations (%) |
|---|---|---|
| 1 | Methirol | 0.73 |
| 2 | Allyl pentanoate | 6.63 |
| 3 | 1,2,5-hexanetriol | 4.88 |
| 4 | 3,3-Diethoxy-1-propyne | 2.91 |
| 5 | Tert-Butyl hydroperoxide | 0.96 |
| 6 | Eucalyptol | 0.50 |
| 7 | Cis-beta-ocimene | 4.25 |
| 8 | Eugenol methyl ether | 60.08 |
| 9 | β-Caryophyllene | 3.26 |
| 10 | α-Craryophyllene | 1.12 |
| 11 | α-Cubebene | 2.55 |
| 12 | α-Farnesene | 11.10 |
| 13 | Caryophyllene oxide | 1.03 |
 | Figure 5: Gas chromatography-mass spectrometry chromatogram of the methanolic extract of the whole plant of Melaleuca spp. [Click here to view] |
3.5. Inhibitory Ability of Vibrio spp.
The inhibitory ability of the extract against Vibrio bacteria was studied using 8 isolates of Vibrio spp.: A2.1, A3, B1.2, B5.1, B8.1, C1.2, C4.3, and C9.1, at concentrations of 100, 75, 50, 25, and 10 mg/mL. The extract showed inhibitory ability against Vibrio at various concentrations [Table 4 and Figure 6].
Table 4: Antibacterial ability of Melaleuca extract.
| Strains | Inhibition halo diameter (mm) | |||||
|---|---|---|---|---|---|---|
| Tetracycline* | 100 mg/mL | 75 mg/mL | 50 mg/mL | 25 mg/mL | 10 mg/mL | |
| Vibrio spp. A2.1 | 26.56±0.40 | 5.93a±0.56 | 4.36b±0.72 | 4.00bc±0.26 | 2.90cd±0.43 | 1.80d±0.34 |
| Vibrio spp. A3 | 25.80±0.26 | 4.43a±0.41 | 4.23a±0.58 | 4.00ab±0.10 | 3.01b±0.08 | 1.30c±0.51 |
| Vibrio spp. B1.2 | 25.30±0.96 | 4.10a±0.26 | 3.90a±0.43 | 2.13b±0.15 | 2.03b±0.15 | - |
| Vibrio spp. B5.1 | 8.16±0.57 | 4.13a±0.11 | 4.03a±0.11 | 4.16a±0.05 | 1.96b±0.15 | - |
| Vibrio spp. B8.1 | 22.33±0.20 | 3.93a±0.15 | 3.93a±0.05 | 3.96a±0.5 | - | - |
| Vibrio spp. C2.1 | 19.23±0.75 | 1.96a±0.05 | 1.93a±0.05 | - | - | - |
| Vibrio spp. C4.3 | 20.23±0.64 | 3.93a±0.05 | 3.96a±0.05 | 2.00b±0.1 | - | - |
| Vibrio spp. C9.1 | 19.76±0.25 | 4.00a±0.00 | 4.00a±0.00 | 3.67a±0.057 | - | - |
“*” Tetracycline is used at 5 mg/mL, “−” non-antibacterial, each treatment was replicated 3 times. Within each row, mean values followed by the same letters represent statistically insignificant differences at the 5% significance level according to Tukey’s test.
| Figure 6: Anti-Vibrio spp. B5.1 ability of Melaleuca extract. [Click here to view] |
All five concentrations inhibited Vibrio A2.1 and A3, with the diameter of the inhibition zone reaching 5.67 mm at a concentration of 100 mg/mL. However, Vibrio sp. C2.1, C4.3, and C9.1 were not inhibited at 10 and 25 mg/mL. When the concentration of extract increased, the diameter of the inhibition zone also increased; these results showing the active compounds in the extract enhanced the resistance against Vibrio spp.
Only high concentrations of the Melaleuca leaves extract inhibited Vibrio spp. According to the Clinical and Laboratory Standards Institute, compounds with significant antibacterial activity usually have minimum inhibitory concentrations (MICs) below 100 µg/mL [20]. However, the effective concentration of Melaleuca extract identified in this study is from 10 to 100 mg/mL, which is higher than the recommended. Antibacterial function can be decreased due to interactions among the various bioactive compounds in the extract. This observation is consistent with the findings of Semeniuc et al. (2012). In particular, strong antibacterial activity was observed in the thyme essential oil when used alone, but this activity was reduced in combination with parsley, celery, or basil because of the antagonism [21]. In another study, 13 chemical components were identified using GC-MS-based phytochemical analysis of methanolic plant extracts. Of these, at least three compounds, 1,8-cineole (eucalyptol), eugenol methyl ether, and β-caryophyllene, showed potential antibacterial properties. According to Yoo and Jwa (2018), β-caryophyllene, a sesquiterpene commonly used in ethnopharmacology, was shown to have significant antibacterial activity; the growth of Streptococcus mutans was inhibited at concentrations ≥0.078% [22]. Moreover, 1,8-cineole has been reported to inhibit biofilm formation and reduce virulence in E. coli O101 by downregulating the expression of the luxS gene, a key component of the population induction mechanism [23]. Beside that, eugenol and its derivatives were identified to have antibacterial and antifungal activities in vitro conditions [24]. In our research, although MIC and minimum bactericidal concentration (MBC) tests were attempted, the high concentration threshold of the crude extract precluded reliable determination. Future work will involve testing individual compounds for accurate MIC/MBC values. Therefore, to standardize and improve the accuracy of MIC and MBC assessments in antimicrobial screening, it is essential to fractionate crude extracts and evaluate the bioactivity of individual constituents, thereby clarifying the specific role and potency of each compound.
The results illustrated that the components and antimicrobial ability of the extract have potential applications in disease prevention and treatment in aquaculture, especially for shrimp diseases. In 2010, WFD in shrimp was reported to cause significant losses to the shrimp farming in the Mekong Delta (Vietnam). One of the most common symptoms is white fecal fibers floating on the water, and the white color of the intestines, which is distinct from the black color of the healthy shrimp [3]. Diseased shrimp often show signs of reduced feed intake, slow growth, discoloration of the hepatopancreas, and loose shrimp shells [25]. The causative factors have been identified as a combination of adverse environmental conditions, bacterial invasion, and microsporidia (EHP) parasites. Notably, intestinal microflora disturbances caused by Vibrio spp., especially V. parahaemolyticus, have been identified as the main agents [26]. A study identified 10 V. parahaemolyticus isolates carrying the toxR virulence gene, along with 14 other Vibrio strains isolated from 30 WFD-affected shrimp samples, highlighting the important role of Vibrio in causing intestinal microbiota dysbiosis - the main mechanism causing WFD in shrimp.
The research observed antibacterial activity from the ethanol extraction of Melaleuca leaves, which contributes to opening a sustainable approach to controlling pathogenic. Melaleuca extraction inhibits Vibrio sp. and V. parahaemolyticus at 25 mg/mL, the pathogen genus in aquaculture. The extract contains more than 50 bioactive compounds, which eucalyptol (27.512%), γ-terpinene (8.59%), terpinolene (9.047%), β-eudesmene (3.359%), α-selinene (3.889%), α-terpineol (4.108%), 1R-α-pinene (2.158%), caryophyllene (6.48%) and α-caryophyllene (3.522%), contributing to their strong antibacterial properties [27].
Finally, Melaleuca leaves extract could be a promising alternative antibiotic. Further studies should elucidate the molecular mechanism, confirm the practicality of mass production, and ensure safety for application.
4. CONCLUSION
The methanol extract of Melaleuca leaves demonstrated the ability to control V. parahaemolyticus strains carrying the virulence gene toxR, as well as other Vibrio spp. isolated from white-leg shrimp affected by WFD. The antibacterial activity became evident at a concentration of 25 mg/mL. Chemical analysis revealed that the extract contains 13 bioactive compounds. Next studies should focus on identifying the compounds against Vibrio and their impact on white-leg shrimp. For industrial applications, it is urgent to optimize the extraction steps, standardize the compounds’ concentration, and develop highly effective and feasible formulations in practical aquaculture.
5. AUTHORS’ CONTRIBUTIONS
All authors made substantial contributions to conception and design, acquisition of data, or analysis and interpretation of data; took part in drafting the article or revising it critically for important intellectual content; agreed to submit to the current journal; gave final approval of the version to be published; and agreed to be accountable for all aspects of the work. All the authors are eligible to be an author as per the International Committee of Medical Journal Editors (ICMJE) requirements/guidelines.
6. FUNDING
There is no funding to report.
7. CONFLICTS OF INTEREST
The authors report no financial or any other conflicts of interest in this work.
8. ETHICAL APPROVALS
This study does not involve experiments on animals or human subjects.
9. DATA AVAILABILITY
All the data is available with the authors and shall be provided upon request.
10. PUBLISHER’S NOTE
All claims expressed in this article are solely those of the authors and do not necessarily represent those of the publisher, the editors and the reviewers. This journal remains neutral with regard to jurisdictional claims in published institutional affiliation.
11. USE OF ARTIFICIAL INTELLIGENCE (AI)-ASSISTED TECHNOLOGY
The authors declare that they have not used artificial intelligence (AI)-tools for writing and editing of the manuscript, and no images were manipulated using AI.
REFERENCES
1. Kim T. Vietnam's Shrimp Exports to the EU Rebound in Q1/2025:Market Diversification Gains Traction amid U.S. Tariff Policies. Seafood VASEP;2025. Available from: https://seafood.vasep.com.vn/key-seafood-sectors/shrimp/news/vietnam-s-shrimp-exports-to-the-eu-rebound-in-q1-2025-market-diversification-gains-traction-amid-u-s-tariff-policies-33445.html [Last accessed on 2025 Jun 10].
2. Aquaculture.vn. In 2022, 22,894 Hectares of Brackish Water Shrimp Farming Area Were Damaged. Aquaculture.vn; 2022.1. Available from: https://aquaculture.vn/thuy-san-viet-nam/nam-2022-22-894ha-dien-tich-nuoi-tom-nuoc-lo-bi-thiet-hai [Last accessed on 2025 Jun 10].
3. Somboon M, Purivirojkul W, Limsuwan C, Chuchird N. Effect of Vibrio spp. in white feces infected shrimp in Chanthaburi, Thailand. KU Fish Res Bull. 2012;36(1):7-15.
4. Supono S, Wardiyanto W, Harpeni E. Identification of Vibrio sp. as a cause of white feces diseases in white shrimp Penaeus vannamei and handling with herbal ingredients in East Lampung Regency, Indonesia. AACL Bioflux. 2019;12(2):417-25.
5. Rahardjo KK, Satyantini WH, Amin, M. Profiling of microbial community in rearing water of white shrimp (Litopenaeus vannamei) infected with white feces disease syndrome. J Aquac Fish Health. 2023;12(2):216-25. [CrossRef]
6. Batubara I, Mitsunaga T, Ohashi H. Screening antiacne potency of Indonesian medicinal plants: Antibacterial, lipase inhibition, and antioxidant activities. J Wood Sci. 2009;55:230-5. [CrossRef]
7. Tran TA, Huynh TP, Nguyen TT, Le TH, Tran TH, Bui TP, et al. Evaluation of the inhibitory activities of COVID-19 of Melaleuca cajuputi oil using docking simulation. ChemistrySelect. 2020;5(21):6312-20. [CrossRef]
8. Isnaini I, Biworo A, Khatimah H, Gufron KM, Puteri SR. Antibacterial and antifungal activity of Galam (Melaleuca cajuputi subsp. cumingiana (Turcz.) Barlow) extract against E. coli bacteria and C. albicans fungi. J Agromed Med Sci. 2021;7(2):79-83. [CrossRef]
9. Khalaf OM, Abdel-Aziz MS, El-Hagrassi AM, Osman AF, Ghareeb MA. Biochemical aspect, antimicrobial and antioxidant activities of Melaleuca and Syzygium species (Myrtaceae) grown in Egypt. J Phys Conf Ser. 2021;1879(2):1-15. [CrossRef]
10. Priya PS, Vaishnavi S, Sreekutty AR, Sudhakaran G, Arshad A, Arockiaraj J. White feces syndrome in shrimp:Comprehensive understanding of immune system responses. Fish Shellfish Immunol. 2024;151:109704. [CrossRef]
11. Shanmugasundaram S, Mayavu P, Manikandarajan T, Suriya M, Eswar A, Anbarasu R. Isolation and identification of Vibrio sp. in the hepatopancreas of cultured white pacific shrimp (Litopenaeus vannamei). Int Lett Nat. 2015;46:52-9. [CrossRef]
12. Montieri S, Suffredini E, Ciccozzi M, Croci L. Phylogenetic and evolutionary analysis of Vibrio parahaemolyticus and V. alginolyticus isolates based on toxR gene sequence. New Microbiol. 2010;33(4):359-72.
13. Kim YB, Okuda JU, Matsumoto C, Takahashi N, Hashimoto S, Nishibuchi M. Identification of Vibrio parahaemolyticus strains at the species level by PCR targeted to the toxR gene. J Clin Microbiol. 1999;37(4):1173-7. [CrossRef]
14. Truong MU, Dao TT, Tu TD. Antimicrobial activity of herbal extracts against Vibrio spp. bacteria isolated from white feces syndrome on white leg shrimp (Litopenaeus vannamei) in some provinces in the Mekong Delta. CTU J Innov Sustain Dev. 2021;13(2):61-8. [CrossRef]
15. Akshaya T, Aravind M, Manoj Kumar S, Divya B. Evaluation of in-vitro antibacterial activity against Gram-negative bacteria using silver nanoparticles synthesized from Dypsis lutescens leaf extract. J Chilean Chem Soc. 2022;67(2):5477-83. [CrossRef]
16. Chang CI, Lee CF, Wu CC, Cheng TC, Tsai JM, Lin KJ. A selective and differential medium for Vibrio alginolyticus. J Fish Dis. 2011;34(3):227-34. [CrossRef]
17. Alhusayni AA, Al-Khikani FH. Growth of different bacteria on thiosulfate citrate bile salts sucrose agar. J Mar Med Soc. 2024;26(2):347-8.
18. Childers BM, Klose KE. Regulation of virulence in Vibrio cholerae: The toxR regulon. Future Microbiol. 2007;2(3):335-44. [CrossRef]
19. Huynh KD. Evaluation of pure characteristics and antibacterial activity of tea tree leaves (Melaleuca leucadendra). Can Tho Univ J Sci. 2011;19:143-8.
20. Clinical and Laboratory Standards Institute. Performance Standards for Antimicrobial Susceptibility Testing. 30th ed. CLSI Supplement M100. Clinical and Laboratory Standards Institute; 2020.
21. Semeniuc CA, Pop CR, Rotar AM. Antibacterial activity and interactions of plant essential oil combinations against Gram-positive and Gram-negative bacteria. J Food Drug Anal. 2017;25(2):403-8. [CrossRef]
22. Yoo HJ, Jwa SK. Inhibitory effects of b-caryophyllene on Streptococcus mutans biofilm. Arch Oral Biol. 2018;88:42-6. [CrossRef]
23. Wang Y, Zhang Y, Song X, Fang C, Xing R, Liu L, et al. 1, 8-Cineole inhibits biofilm formation and bacterial pathogenicity by suppressing luxS gene expression in Escherichia coli. Front Pharmacol. 2022;13:988245. [CrossRef]
24. Atanasova-Pancevska N, Bogdanov J, Kungulovski D. Antimicrobial activity and chemical composition of two essential oils and eugenol from flower buds of Eugenia caryophyllata. Open Biol Sci J. 2017;3:16-25. [CrossRef]
25. Piamsomboon P, Han JE. White feces syndrome, a multifactorial syndrome of cultured shrimp: A mini review. Fishes. 2022;7(6):339. [CrossRef]
26. Boopathi S, Meenatchi R, Brindangnanam P, Sudhakaran G, Coumar MS, Arockiaraj J. Microbiome analysis of Litopenaeus vannamei reveals Vibrio as main risk factor of white faeces syndrome. Aquaculture. 2023;576:739829. [CrossRef]
27. Tran QT, Lai PP, Nguyen QC, Nguyen TH, Doan LP, Trinh TH, et al. Determination of chemical composition and antimicrobial activity of Melaleuca cajuputi essential oil from Quang Tri province, Vietnam. Asian J Chem. 2020;32(9):2203-7. [CrossRef]